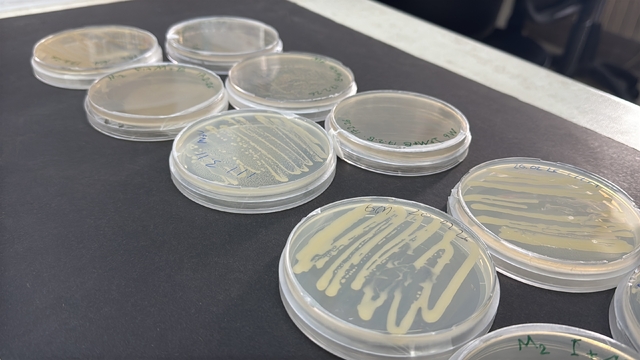
Galeri
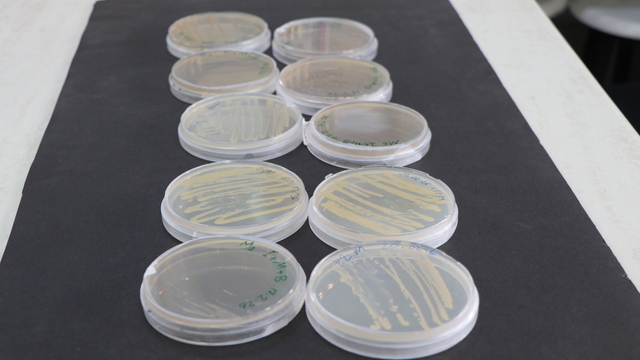
Galeri

Türk bilim insanları, Antarktika'daki mikroorganizmaları tarıma kazandırmayı hedefliyor
SAMSUN Ondokuz Mayıs Üniversitesi'nden (OMÜ) Dr.

SAMSUN Ondokuz Mayıs Üniversitesi’nden (OMÜ) Dr. Öğr. Üyesi Yılmaz Kaya, Antarktika’dan alınan mikroorganizmaları tarıma kazandırabilmek için araştırmalar yapacaklarını belirterek, “Bölgedeki bazı faydalı mikroorganizmalar, OMÜ bünyesindeki laboratuvarlarda izole edilecektir. Ardından moleküler olarak tanımlama çalışmaları yapılacaktır. Sonraki aşamada ise bu bakterilerin tarımsal biyoteknolojide kullanılıp kullanılamayacağı araştırılacaktır” dedi.
TÜBİTAK desteğiyle yürütülen proje kapsamında, OMÜ Ziraat Fakültesi Tarımsal Biyoteknoloji Bölümü Dr. Öğr. Üyesi Yılmaz Kaya koordinesinde, Ziraat Fakültesi Tarımsal Biyoteknoloji Bölümü Dr. Öğr. Üyesi Ayşe Feyza Tufan Dülger ve Ziraat Fakültesi Bitki Koruma Bölümü Öğretim Üyesi Prof. Dr. Hasan Murat Aksoy’un yer aldığı araştırma grubu tarafından Antarktika’dan alınan mikroorganizma örnekleri, tarımda kullanılma potansiyellerinin belirlenmesi amacıyla laboratuvarda incelenecek. Bu kapsamda mikroorganizmalar izole edilerek moleküler olarak tanımlanacak ve bitkiler üzerinde olası patojen etkilerinin bulunup bulunmadığı araştırılacak. OMÜ koordinasyonunda yürütülen çalışmada, Marmara Üniversitesi Fen Fakültesi Biyoloji Bölümü Öğretim Üyesi Prof. Dr. İbrahim İlker Özyiğit ile Universiti Teknologi Malaysia (UTM) Fen Fakültesi Kimya Bölümü'nden Doç. Dr. Roswanira Abd Wahab da ortak araştırmacı olarak yer alıyor. Antarktika’da yüksek toleranslı bitkiler ve mikroorganizmalar olduğunu söyleyen Dr. Öğr. Üyesi Kaya, “Şu an kabul edilen projemiz, TÜBİTAK kapsamında, kutuplarda Antarktika bölgesinde bulunan mikroorganizmaların izolasyonu ve bunların tarımsal biyoteknolojide kullanımıyla ilgili bir projedir. Antarktika doğal bir ekosistemdir, adeta doğal bir laboratuvardır” diye konuştu.
‘İZOLE EDİLEN BAKTERİLER, LABORATUVARDA İNCELEMEDEN GEÇECEK’
Alınan mikroorganizma örneklerinin detaylı şekilde incelemeden geçeceğini belirten Dr. Yılmaz Kaya, “Proje kapsamında bölgedeki bazı faydalı mikroorganizmalar, OMÜ bünyesindeki laboratuvarlarda izole edilecektir. Ardından moleküler olarak tanımlama çalışmaları yapılacaktır. Sonraki aşamada ise bu bakterilerin tarımsal biyoteknolojide kullanılıp kullanılamayacağı araştırılacaktır. Günümüzde yoğun modern tarım uygulamalarında kimyasal gübreler ve çeşitli kimyasal girdiler kullanılmaktadır. Bu mikroorganizmaların bu girdilere alternatif olup olamayacağı değerlendirilecektir. Özellikle soğuk atmosfer koşullarında yaşayabilir mi, azot fiks edebilir mi, fosfor fiks edebilir mi sorularına yanıt aranacaktır. Türkiye’de soğuk iklim bitkilerinde yürütülen çalışmalarda yaygın olarak kimyasal gübreler kullanılmakta ve bu gübrelerin bazı yan etkileri ortaya çıkabilmektedir. Bu nedenle alternatif bir yöntem geliştirilmesi hedeflenmektedir. Antarktika’dan izole edilen bakteriler, OMÜ Ziraat Fakültesi Tarımsal Biyoteknoloji Laboratuvarı’nda tanılama ve moleküler karakterizasyon süreçlerinden geçirilecektir. Bitki koruma bölümünde ise bu mikroorganizmaların bitkiler üzerinde doğal bir düşmanlık oluşturup oluşturmadığı, patojen etkilerinin bulunup bulunmadığı araştırılacaktır. Ayrıca tütün bitkisi ve geleneksel olarak yetiştirilen diğer bitkiler üzerinde herhangi bir yan etki oluşturup oluşturmadıkları incelenecektir” ifadelerini kullandı.
‘BİYOKONTROL AJANI OLARAK KULLANILIP KULLANILAMAYACAĞI DEĞERLENDİRİLECEK’
Projenin araştırma sürecinden bahseden Dr. Kaya, şöyle konuştu:
“Patojen olmadıkları tespit edilirse bir sonraki aşamaya geçilecektir. Bu aşamada söz konusu bakterilerin biyokontrol ajanı olarak kullanılıp kullanılamayacağı değerlendirilecektir. Örneğin elde edilen bir bakterinin fusaryum patojenine karşı antagonistik etki gösterip göstermediği araştırılacaktır. Laboratuvar şartlarında elde edilmiş ve belirli özellikleri kanıtlanmış mikroorganizmalar bulunmaktadır. Bu mikroorganizmaların doğal ortam koşullarında bitkiler üzerinde gerçekten etkili olup olmadıkları da araştırılacaktır. Bu çalışmalar Marmara Üniversitesi Fen Fakültesi Biyoloji Bölümü’nde yürütülecektir. Bunun yanı sıra bazı genler incelenecek, genom düzeyinde araştırmalar gerçekleştirilecektir. Bu düzeydeki çalışmalar ise Malezya Teknoloji Üniversitesi Fen Fakültesi Kimya Bölümü’nde yapılacaktır.”
Faydalı bakterilerin, bitki gelişimini teşvik eden bakteriler olduğunu ifade eden Prof. Dr. Hasan Murat Aksoy da “Toprakta bitkiler tarafından doğrudan kullanılamayan besin elementlerini ayrıştırarak bitkilerin alabileceği forma dönüştürürler. Bu özellikleri nedeniyle bizim için önem taşırlar. Bu grupta ayrıca biyolojik mücadelede kullanılan bakteriler de vardır. Bunlar, hastalık ve zararlıları engelleyen ya da ortadan kaldıran bakterilerdir. Kutup projesi kapsamında elde edeceğimiz izolatların hem bitki gelişimini teşvik edip etmediğini hem de biyolojik mücadele ajanı olarak kullanılıp kullanılamayacağını araştıracağız. Bu çalışmaları biyoteknoloji laboratuvarı ile bitki koruma bakterioloji laboratuvarında yürüteceğiz” dedi.
Anadolu Ajansı, DHA ve İHA tarafından geçilen tüm Samsun haberleri, bu bölümde Haberturk.com editörlerinin hiçbir editoryal müdahalesi olmadan otomatik olarak ajans kanallarından geldiği şekliyle yer almaktadır. Samsun Haberleri alanında yer alan haberlerin hepsinin hukuki muhatabı haberi geçen ajanslardır.